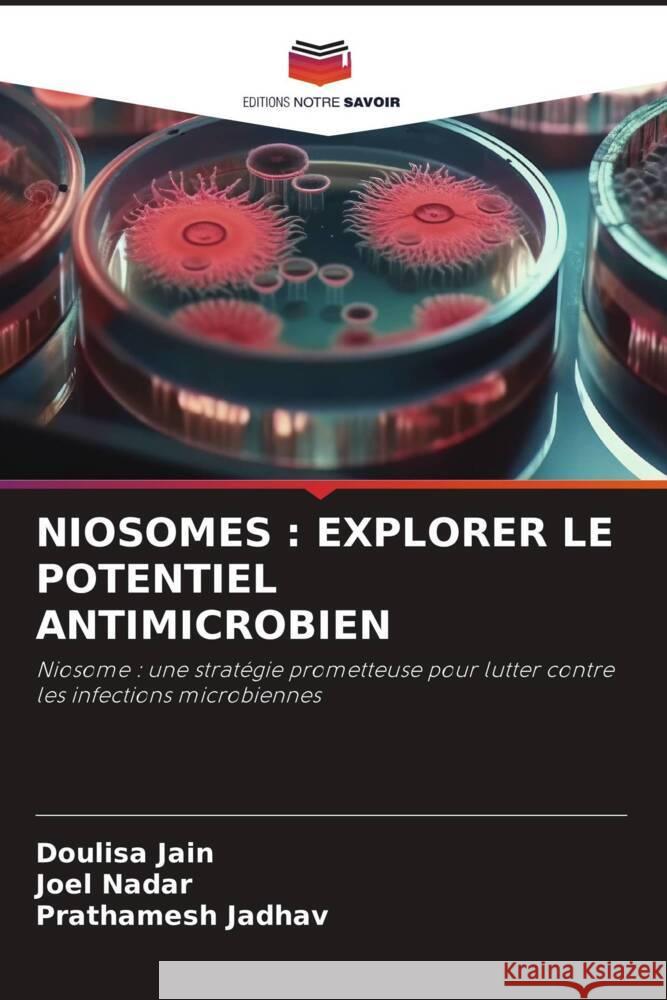
NIOSOMES : EXPLORER LE POTENTIEL ANTIMICROBIEN Jain, Doulisa, Nadar, Joel, Jadhav, Prathamesh 9786208332327 Editions Notre Savoir - książka

NIOSOMES : EXPLORER LE POTENTIEL ANTIMICROBIEN » książka
NIOSOMES : EXPLORER LE POTENTIEL ANTIMICROBIEN
ISBN-13: 9786208332327 / Francuski / Miękka / 2024 / 76 str.
Ce livre propose une exploration approfondie des noisomes, un système innovant d'administration de médicaments, englobant leur ultrastructure, différentes techniques de préparation et leur caractérisation. Il passe également en revue leur large éventail d'applications dans divers secteurs. Des sections détaillées examinent l'efficacité des niosomes dans la lutte contre les infections bactériennes, parasitaires et fongiques, fournissant des informations précieuses pour faire progresser les stratégies thérapeutiques. Le dernier chapitre explore des pistes de recherche prospectives, faisant de cette ressource un outil indispensable pour les chercheurs, les professionnels de la santé et les étudiants engagés dans des études sur l'administration de médicaments et le traitement antimicrobien.